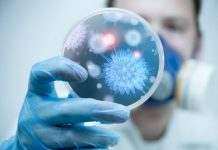
Учёным удалось выяснить, как действует ротавирус

Архіви по місяцях: Квітень 2020
Жуткое убийство ребёнка под Харьковом: появились подробности
Появились подробности страшного убийства, совершённого в селе Подворки Дергачёвского района Харьковской области. Женщина, по версии следствия, зарезала свою тринадцатилетнюю дочь, а потом отрезала...
COVID-19 в мире: ряд стран заявляют, что пик пройден
Состоянием на 20:30 30 апреля в мире, согласно с информацией института системных исследований и инжиниринга Университета Джонса Хопкинса, зафиксировано 3 231 701 случай инфицирования...
В Великобритании ускорили испытание вакцины против коронавируса
В Великобритании ускорили испытания вакцины против COVID-19. На данный момент специалисты кафедры педиатрии Оксфордского университета завершают вакцинацию около восьмисот добровольцев, пишет Информ-UA.
Среди тех, кто...
В Днепре распространили информацию об адресах заражённых
В Днепре создали интерактивную карту адресов, где проживают люди, которые больны коронавирусом. Размещена она на сайте городского совета. Всего в областном центре таких домов...
Чехия переживает самую сильную засуху за последние 500 лет
Чехия переживает самую сильную засуху за последние пятьсот лет. Обильных осадков на протяжении длительного времени нет, а температура воздуха остаётся достаточно высокой, вследствие чего...
COVID-19 лишит средств к существованию 1,6 млрд человек, – МОТ
По прогнозам Международной организации труда, вследствие продления многими странами карантинных ограничений, введённых в связи с пандемией коронавирусной инфекции, ситуация с безработицей будет стремительно ухудшаться....
Заседание ВР: агрессия РФ, долги “Энергорынка” и закон о банках
Сегодня, 30 апреля состоялось внеочередное заседание парламента, на котором был рассмотрен ряд законопроектов и постановлений. В частности, нардепы одобрили спецпроцедуру рассмотрения во втором чтении...
В Украине – более десяти тысяч заболевших коронавирусом
В Украине, согласно с информацией Министерства здравоохранения, состоянием на 15:00 30 апреля зафиксировано 10 406 случаев инфицирования коронавирусом COVID-19, выздоровели 1 238 пациентов. Умер...
В Харькове женщина носила в пакете отрезанную голову дочери
В городе Харьков на улице прохожие заметили странную женщину, которая была абсолютно голой. В руках у этой женщины был пакет и нож. Ввиду странности...
Урожай озимых в Украине будет, несмотря на засуху
Несмотря на сложные погодные условия, в Украине всё-таки будет урожай озимых культур. Правда, не везде. Сложная ситуация сложилась лишь в южных регионах нашей страны....
В Южной Корее из-за пожара на стройке погибли десятки рабочих
В Южной Корее произошёл смертельный инцидент, который унёс жизни по меньшей мере 38 людей. Они погибли, спасаясь от масштабного пожара, возникшего на одной из...
Самолёт, которым хвастался Зеленский, перевозил коммерческий груз
23 апреля в Украину была доставлена очередная партия груза из Китая. На борту самолёта находились маски, защитные костюмы, очки. Президент Владимир Зеленский торжественно заявлял,...
Днепровские велосипедисты сняли обучающие видеоролики
В Днепре ассоциация велосипедистов снимает обучающие видеоролики. В них велосипедисты показывают, как проезжать наиболее опасные маршруты города. Они проезжают сложные перекрёстки, магистрали и подъёмы...
В Киевской области пьяный водитель “скорой” попал в ДТП
В Киевской области в дорожно-транспортное происшествие попал автомобиль скорой помощи. Согласно информации полиции, водитель находился, судя по всему, в состоянии алкогольного опьянения. Считается, что...
Учёным удалось выяснить, как действует ротавирус
Учёным из США удалось выяснить, как именно действует ротавирус. Результаты данного исследования помогут разработать новое лекарство от инфекции, из-за которого ежегодно умирает около 200...
Мимо Земли пролетел астероид: за неделю ожидается ещё 13 таких
В Национальном управлении по аэронавтике и исследованию космического пространства (NASA) отчитались о том, что мимо нашей планеты успешно пролетел астероид. Его скорость движения была...
С 30 апреля в Украине заработают 872 продовольственных рынка
Работа продовольственных рынков была практически главным требованием населения страны. Правительство Украины в ходе сегодняшнего заседания приняло решение позволить рынкам вновь возобновить работу, правда с...
В мире растёт количество случаев незапланированных беременностей
По данным, озвученным в ООН, количество случаев незапланированных зачатий в мире может вырасти на 7 миллионов. Причина этому – карантин, введённый в большинстве странах...
В мире вылечились от коронавируса почти миллион человек
Состоянием на 14:00 29 апреля, согласно с информацией центра системных исследований и инжиниринга Университета Джонса Хопкинса, в мире зафиксировано 3 127 519 случаев инфицирования...
Солнце и алкоголь: в Минздраве опровергли мифы о COVID-19
В Центре общественного здоровья Министерства здравоохранения Украины опровергли в очередной раз некоторые мифы, связанные с коронавирусной инфекцией COVID-19. Речь идёт о путях передачи коронавируса,...
В Украине у многих больных COVID-19 тромбоэмболические осложнения
В Украине состоянием на 12:00 29 апреля, согласно с информацией Министерства здравоохранения, коронавирусом COVID-19 инфицировались 9 866 человек. Зафиксировано 250 летальных случаев, выздоровели 1...
Кабмин не подавал представление о назначении Саакашвили, – Мокан
Вчера, 28 апреля в СМИ появилась информация о том, что якобы Кабинет министров отозвал своё представление о кандидатуре Михеила Саакашвили на должность вице-премьер-министра Украины...
Земельні ділянки для атовців Кам’янського
Мер Кам'янського Андрій Білоусов вручив документи першим десяти атовцям з Кам'янського, які підтверджують їхнє право володіти земельними ділянками, які знаходяться у селі Сотницьке на території Петриківської ОТГ, що розташоване поруч з Кам'янським.
Полегшення для малого і середнього бізнесу
Розуміючи проблеми приватного підприємництва, чимало представників місцевого самоврядування вирішили піти назустріч малому та середньому бізнесу, шукаючи хоча б мінімальне полегшення для його виживання у подальшому.